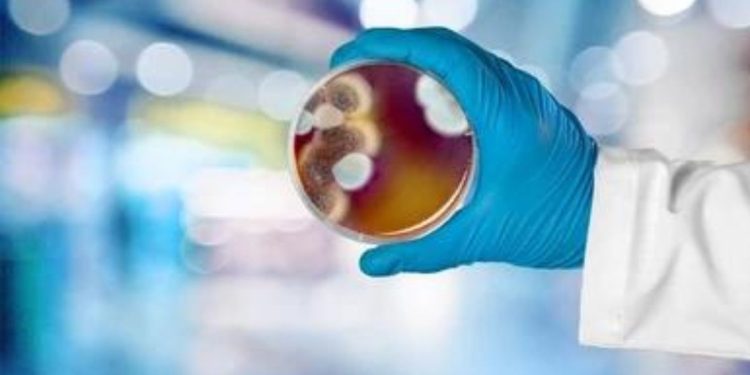
Mold Testing

A Comprehensive Guide to the Medical Marijuana Card Process
Key Takeaways Understanding New Jersey's medical marijuana card application process Preparing necessary documents and finding healthcare providers Legal considerations, patient's rights, and renewal of the card The role of telehealth and staying updated with regulations Table of Contents Understanding the Medical Marijuana Program in New Jersey Preparation: What You Need Before Starting Step-by-Step Application Process Navigating the State's...